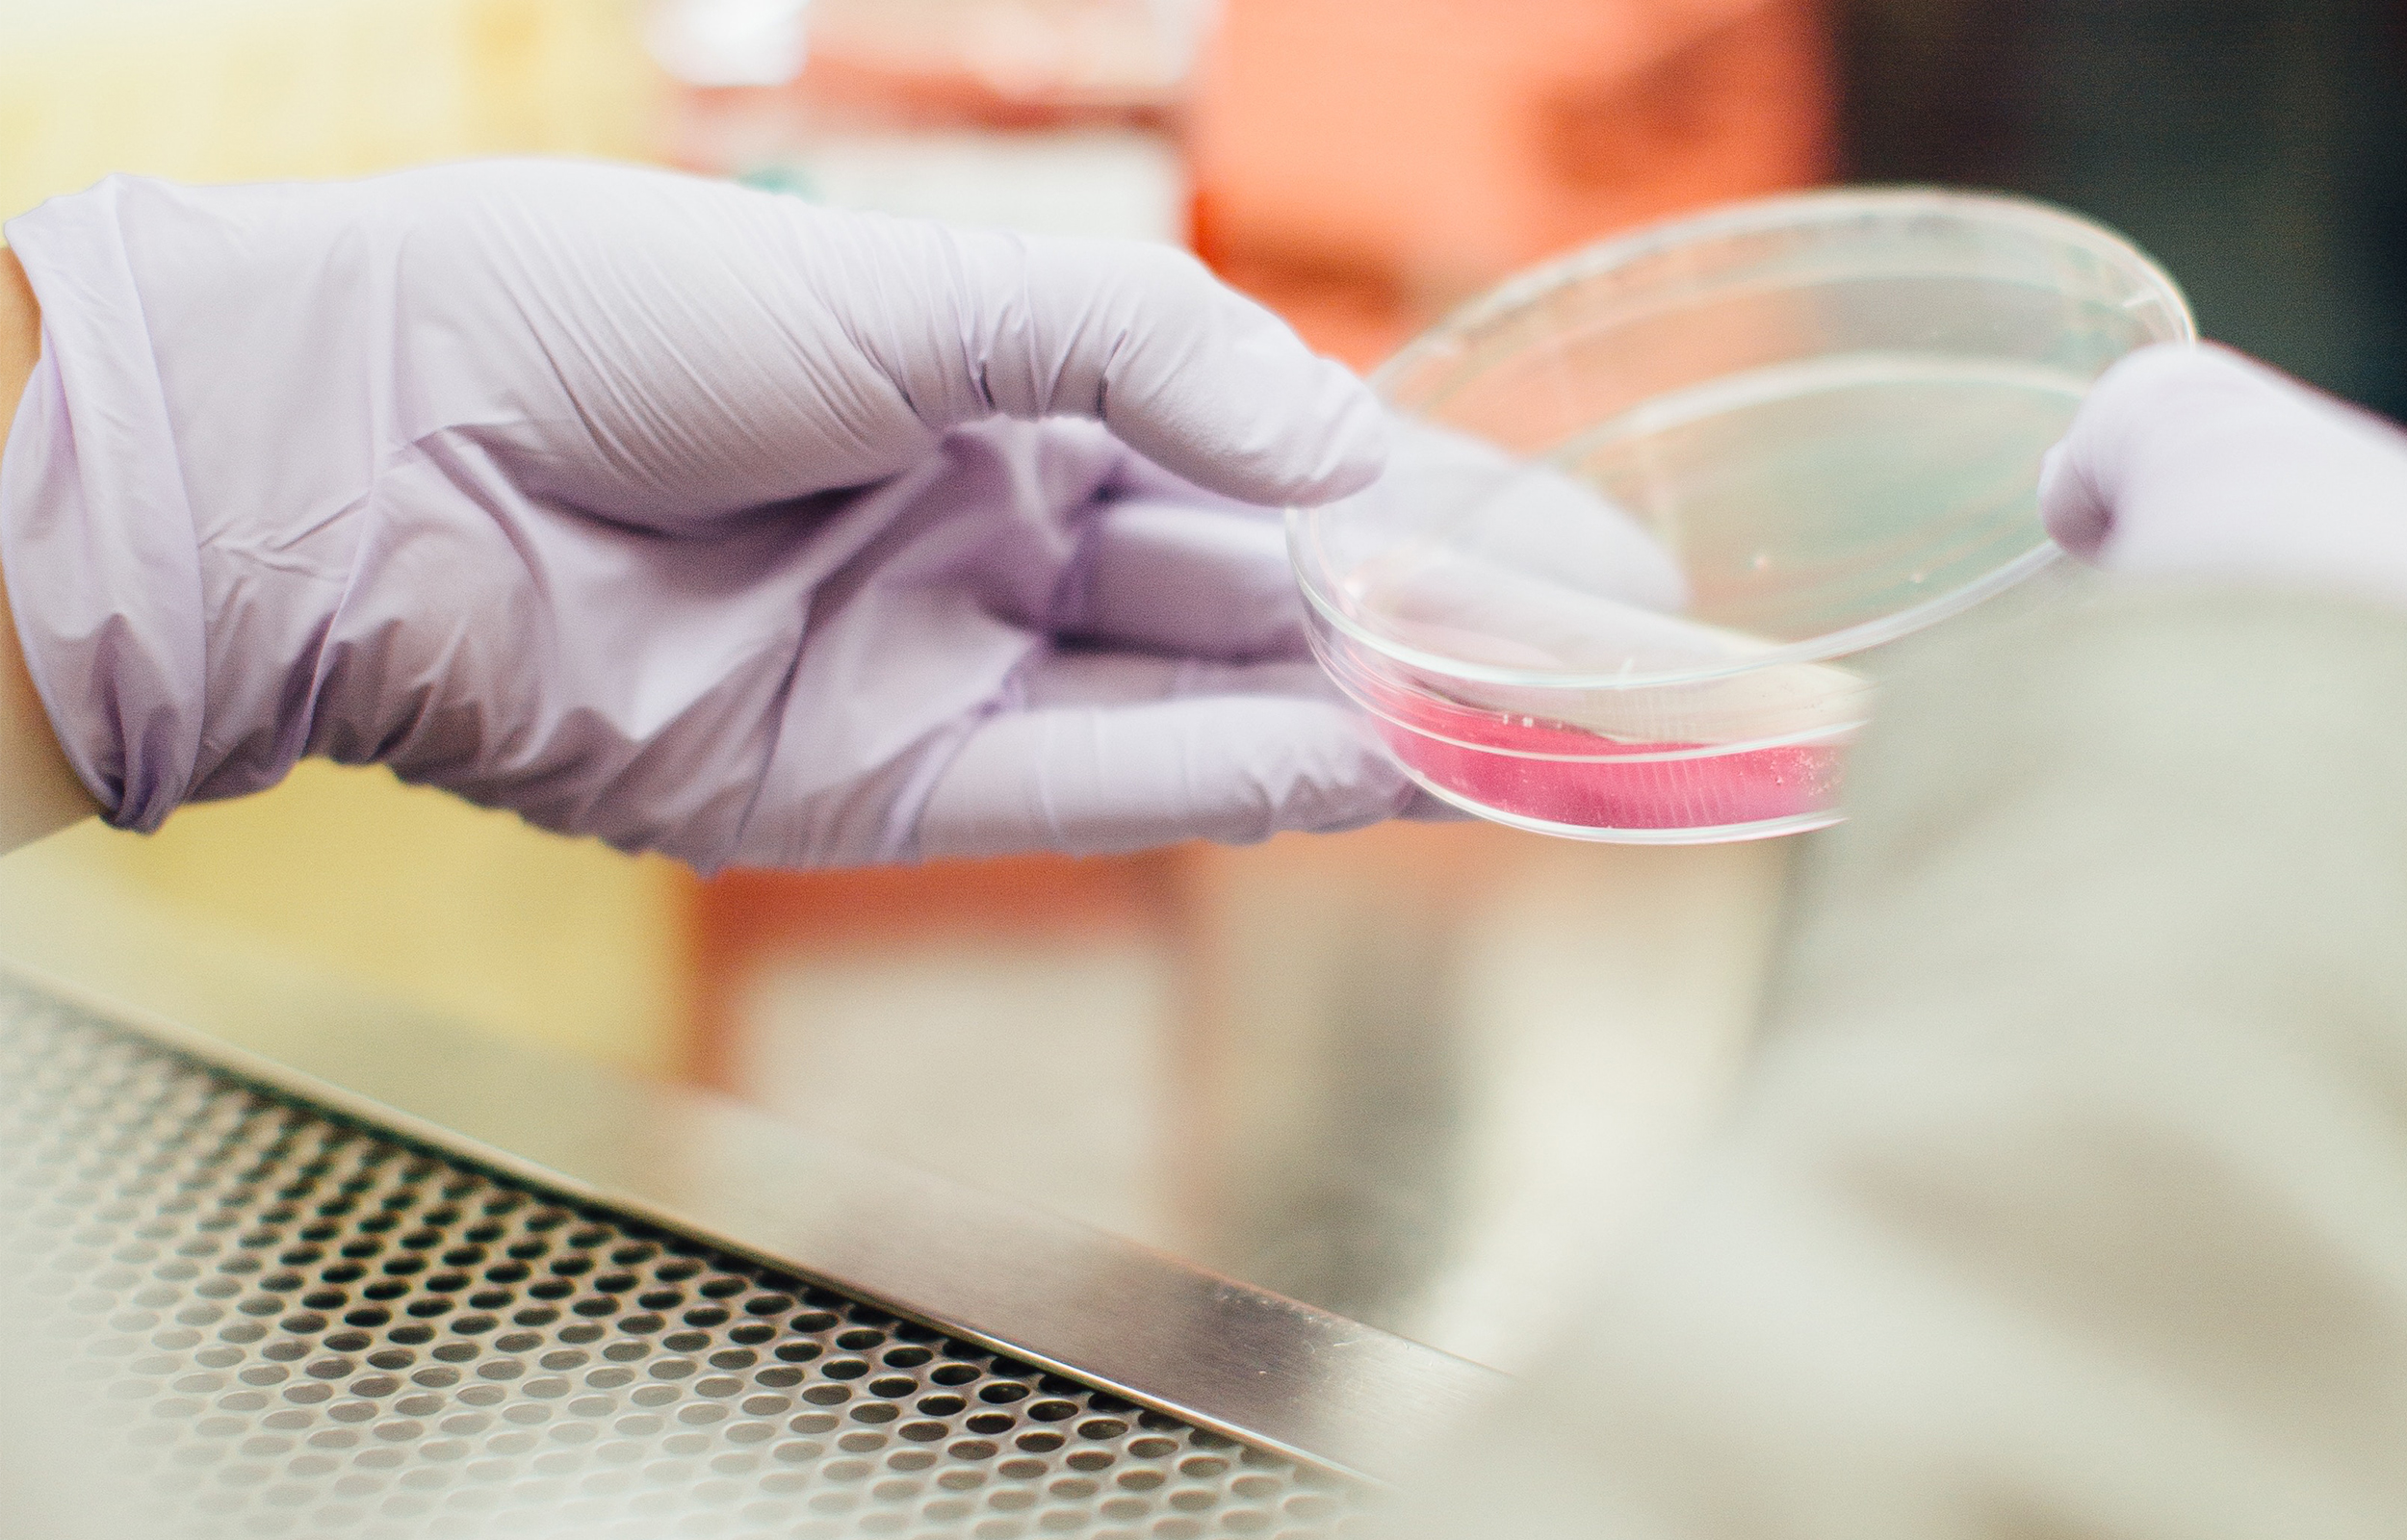
Lay Bible Institute

Ever had a conversation where you were caught off guard by an assumption of modern science that seemed to deny the truth of God’s Word? Guest Rev. Dr. Joel Okamoto, the Waldemar and Mary Griesbach Professor of Systematic Theology, chairman of the Department of Systematic Theology and associate professor of Systematic Theology at Concordia Seminary, St. Louis, talks about the upcoming Summer Lay Bible Institute at Concordia Seminary on August 5, 2017, titled “What Christians in a Scientific Age Should Know about Theology.” What are some of the assumptions of modern science that we should be prepared to deal with in our theology? How do these assumptions affect the methods and findings of modern science? Is our use of language or vocabulary important to consider when we confess our faith? Learn more about the Institute and register at csl.edu/resources/continuinged/lay-bible-institute.
 Send in your family questions to Family@kfuo.org or call host Andy Bates at (314) 996-1519.
Send in your family questions to Family@kfuo.org or call host Andy Bates at (314) 996-1519.